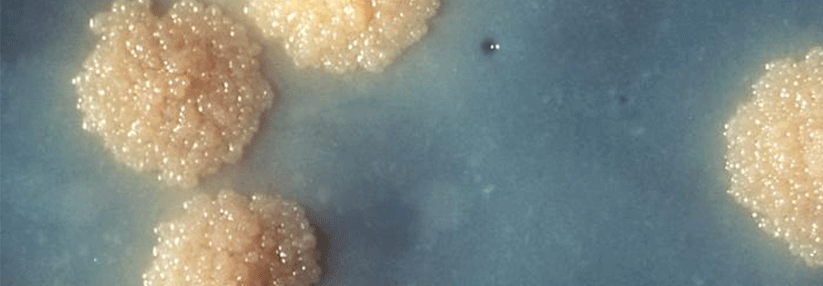

Extrapulmonale Tuberkulose Ein Puzzle aus Symptomen und Befunden
 Da bei extrapulmonaler Tuberkulose das Negativwerden des Sputums als Monitoringfaktor ungeeignet ist, müssen Klinik und ggf. die Bildgebung zur Beurteilung des Therapieeffektes herangezogen werden.
© wikimedia/Yale Rosen
Da bei extrapulmonaler Tuberkulose das Negativwerden des Sputums als Monitoringfaktor ungeeignet ist, müssen Klinik und ggf. die Bildgebung zur Beurteilung des Therapieeffektes herangezogen werden.
© wikimedia/Yale Rosen
Die Tuberkulose ist bei uns selten geworden, man muss also erst einmal an sie denken, erklärte PD Dr. Isabelle Suárez vom MVZ der Uniklinik Köln. Etwa 71 % der Betroffenen entwickeln eine pulmonale Tbc, bei etwa jedem fünften von ihnen sind zusätzlich andere Organe befallen. In 28,6 % der Fälle liegen ausschließlich extrapulmonale Manifestationen vor. Ihre Häufigkeit hat laut RKI-Daten seit 2002 kontinuierlich zugenommen. Sie finden sich zumeist in extra- und intrathorakalen Lymphknoten sowie in der Pleura. Grundsätzlich kann aber jedes Organsystem in Mitleidenschaft gezogen sein. Es resultiert daher eine Vielzahl unterschiedlicher Symptome, was die Diagnostik zu einem Puzzle macht.
Vom…
Bitte geben Sie Ihren Benutzernamen und Ihr Passwort ein, um sich an der Website anzumelden.






